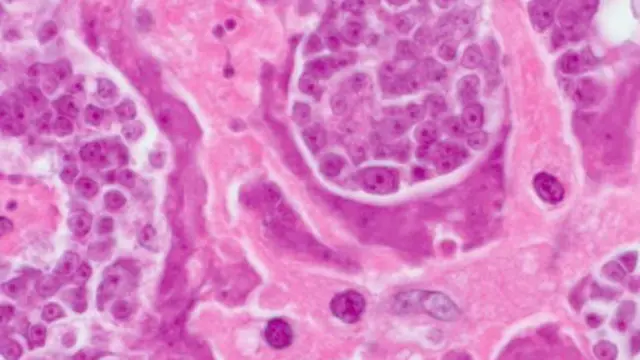

মস্তিষ্কের ভেতর বাস করছিলো জীবন্ত কৃমি

ছবির উৎস, AP
যুক্তরাষ্ট্রের ক্যালিফোর্নিয়ায় চিকিৎসকরা এক ব্যক্তির মস্তিষ্ক থেকে জীবন্ত ফিতা কৃমি অপসারণ করেছেন।
প্রচণ্ড মাথা ব্যথা নিয়ে হাসপাতালে ভর্তি হয়েছিলেন লুইস অর্টিজ নামক ওই ব্যক্তি।
ব্রেইন স্ক্যান করার পর তার রিপোর্ট দেখে নিউরোসার্জন যা বললেন তাতে তার চোখ ছানাবড়া।
কারণ রিপোর্টে দেখাচ্ছিল একটি জীবন্ত ফিতাকৃমি বসবাস করছে লুইস অর্টিজের মস্তিষ্কে।
সেটি দেখে চিকিৎসক বললেন ত্রিশ মিনিটের মধ্যে এটি বের না করলে মৃত্যু অনিবার্য।

ছবির উৎস, SPL
মস্তিষ্কের মধ্যে একটি ছোট টিউমারের মধ্যে বেড়ে উঠছিলো সেটি। আর সে কারণেই মস্তিষ্কের ভেতরে পানির প্রবাহে বাধা সৃষ্টি হচ্ছিলো।
“পরে ডাক্তার যখন এটি বের করলেন তখনও কিলবিল করছিলো সেটি”, বলছিলেন মি. অর্টিজ।
গত অগাস্টে সার্জারির পর এখন ক্রমশ সুস্থ হয়ে উঠছেন তিনি এবং আশা করছেন খুব শিগগিরই আবার বিশ্ববিদ্যালয়ের পড়ায় ফিরে যেতে পারবেন তিনি।
কিন্তু তার মস্তিষ্কে ফিতা কৃমি গেলো কি করে ?
ছবির উৎস, CDC
যুক্তরাষ্ট্রের গবেষকরা বলছেন একবার কোন খাদ্য খেয়ে কিংবা অন্য কোন উপায়ে কৃমির একবার পাকস্থলীতে গেলে সেটি পরবর্তীতে নিজ থেকে মস্তিষ্ক পর্যন্ত যাওয়ার পথ তৈরি করে নিতে পারে।
মি. অর্টিজের ক্ষেত্রেও সেটি হয়েছিলো।
যুক্তরাষ্ট্রে প্রতি বছর প্রায় এক হাজার মানুষ এ ধরনের ঘটনায় অপারেশনের টেবিলে যেতে হয়।








